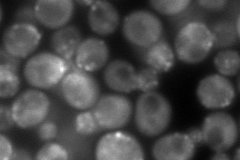
YLR429W

View description
Coronin, cortical actin cytoskeletal component that associates with the Arp2p/Arp3p complex to regulate its activity; plays a role in regulation of actin patch assembly
Localization:
Intensity:
Fold change:
Significance:
-
C’ GFP library in SD

punctate65.71 -
N' NOP1pr-GFP in SD

punctate184.041 -
N' TEF2pr-mCherry in SD
punctate,bud neck250.739 -
N' NATIVEpr-GFP in SD

punctate30.8297 -
N' TEF2pr-VC and Cyto-VN in SD

punctate,bud neck72.6248 -
C’ GFP library in SD+DTT

punctate85.971.3No -
C’ GFP library in SD+H2O2

punctate79.111.2No -
C’ GFP library in Starvation Media

punctate78.11.18No -
C’ GFP library on the background of Pup2-DaMP

punctate -
C’ GFP library on the background of CCT mutant

punctate76.8011.16859No
